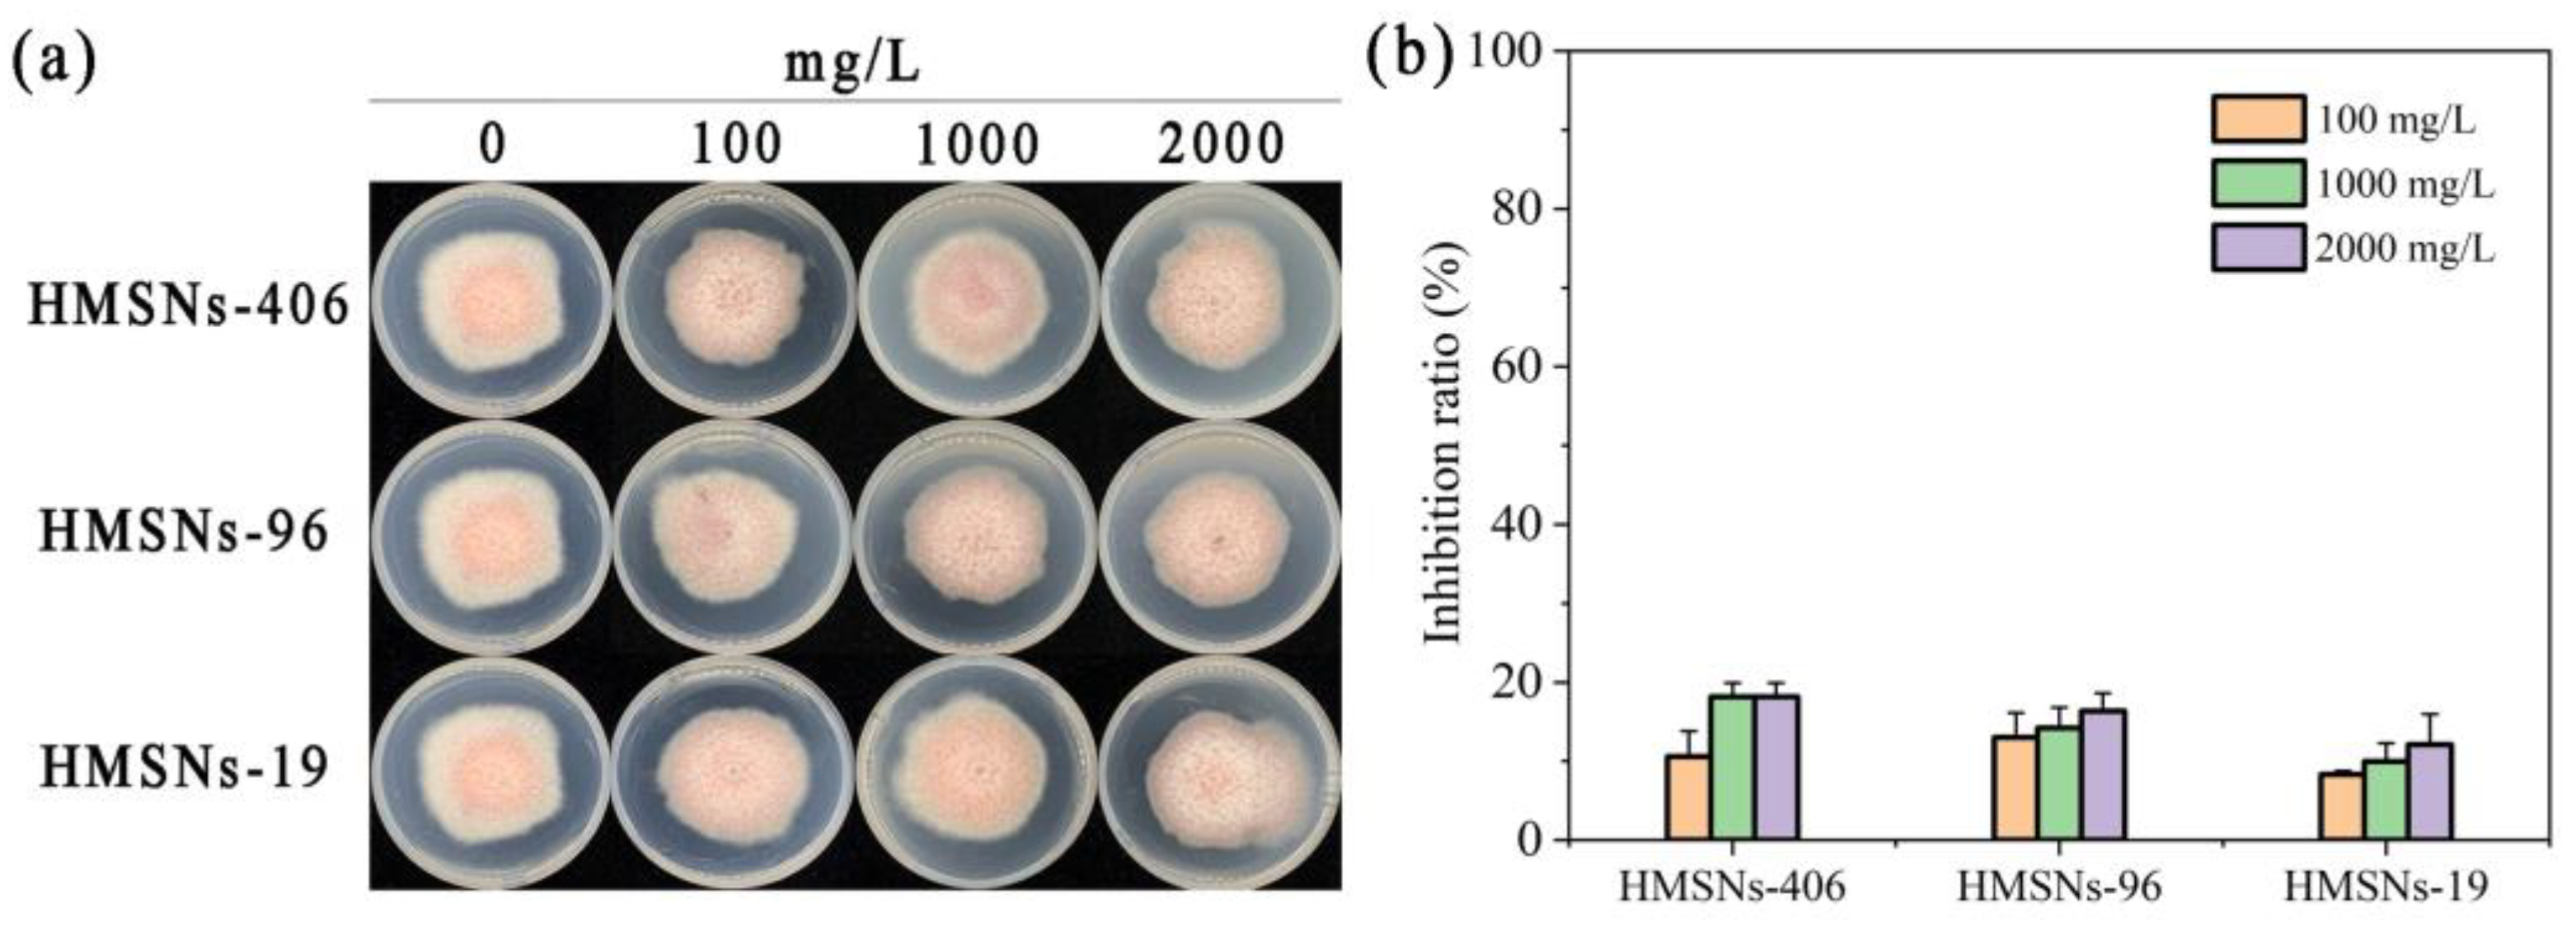
Ijms 25 04514 g004

Hollow Mesoporous Silica Nanoparticles as a New Nanoscale Resistance Inducer for Fusarium Wilt Control: Size Effects and Mechanism of Action
Abstract
1. Introduction
2. Results
2.1. Characterization of Hollow Mesoporous Silica Nanoparticles (HMSNs)
2.2. Effect of HMSNs on Cowpea Seed Germination and Growth
2.3. Effect of HMSNs on FOP Mycelial Growth
2.4. Effect of HMSNs on the Disease Incidence
2.5. Effect of Foliar HMSNs-406 Application on Cowpea Root Salicylic Acid (SA) Content
2.6. Gene Expression Changes after Foliar Exposure of HMSNs-406
2.7. Changes in Defense-Related Enzyme Activity
3. Discussion
4. Materials and Methods
4.1. Materials
4.2. Synthesis of Hollow Mesoporous Silica Nanoparticles (HMSNs)
4.3. Electron Microscopy Observation
4.4. Dynamic Light Scattering (DLS) and Zeta Potential Measurements
4.5. Monitoring Seed Germination and Seedling Growth after HMSNs Treatment
4.6. Mycelial Growth Inhibition Test
4.7. Pot Experiments
4.8. Salicylic Acid (SA) Measurement
4.9. Gene Expression Variations
4.10. Defense-Responsive Enzyme Activity Measurement
4.11. Statistical Analysis
5. Conclusions
Supplementary Materials
Author Contributions
Funding
Institutional Review Board Statement
Informed Consent Statement
Data Availability Statement
Acknowledgments
Conflicts of Interest
References
- Dutta, P.; Kumari, A.; Mahanta, M.; Upamanya, G.K.; Heisnam, P.; Borua, S.; Kaman, P.K.; Mishra, A.K.; Mallik, M.; Muthukrishnan, G.; et al. Nanotechnological approaches for management of soil-borne plant pathogens. Front. Plant Sci. 2023, 14, 1136233. [Google Scholar] [CrossRef] [PubMed]
- Sampaio, A.M.; Araújo, S.d.S.; Rubiales, D.; Vaz Patto, M.C. Fusarium wilt management in legume crops. Agronomy 2020, 10, 1073. [Google Scholar] [CrossRef]
- Cunha, W.L.; Andrade Leonel, M.R.d.S.; de Sousa, A.P.B.; Lima, M.A.d.S.; Santos, A.d.J.M.; Nascimento, G.M.d.; Mochel, G.d.M.S.; Silva, S.L.O.; Nobre, C.P.; Rodrigues, A.A.C.; et al. Arbuscular mycorrhizal fungi can reduce severity of fusariosis (Fusarium oxysporum) in cowpea plants (Vigna unguiculata (L.) Walp.). Rhizosphere 2023, 28, 100795. [Google Scholar] [CrossRef]
- Hao, Y.; Li, Y.; Ping, X.; Yang, Q.; Mao, Z.; Zhao, J.; Lu, X.; Xie, B.; Yang, Y.; Ling, J. The genome of Fusarium oxysporum f. sp. phaseoli provides insight into the evolution of genomes and effectors of Fusarium oxysporum species. Int. J. Mol. Sci. 2023, 24, 963. [Google Scholar] [PubMed]
- Durrant, W.E.; Dong, X. Systemic acquired resistance. Annu. Rev. Phytopathol. 2004, 42, 185–209. [Google Scholar] [CrossRef] [PubMed]
- Mauch, F.; Mauch-Mani, B.; Gaille, C.; Kull, B.; Haas, D.; Reimmann, C. Manipulation of salicylate content in Arabidopsis thaliana by the expression of an engineered bacterial salicylate synthase. Plant J. 2001, 25, 67–77. [Google Scholar] [CrossRef] [PubMed]
- El-Shetehy, M.; Moradi, A.; Maceroni, M.; Reinhardt, D.; Petri-Fink, A.; Rothen-Rutishauser, B.; Mauch, F.; Schwab, F. Silica nanoparticles enhance disease resistance in Arabidopsis plants. Nat. Nanotechnol. 2021, 16, 344–353. [Google Scholar] [CrossRef] [PubMed]
- Ahammed, G.J.; Yang, Y. Mechanisms of silicon-induced fungal disease resistance in plants. Plant Physiol. Biochem. 2021, 165, 200–206. [Google Scholar] [CrossRef]
- Kang, H.; Elmer, W.; Shen, Y.; Zuverza-Mena, N.; Ma, C.; Botella, P.; White, J.C.; Haynes, C.L. Silica nanoparticle dissolution rate controls the suppression of Fusarium wilt of watermelon (Citrullus lanatus). Environ. Sci. Technol. 2021, 55, 13513–13522. [Google Scholar] [CrossRef]
- Buchman, J.T.; Elmer, W.H.; Ma, C.; Landy, K.M.; White, J.C.; Haynes, C.L. Chitosan-coated mesoporous silica nanoparticle treatment of Citrullus lanatus (Watermelon): Enhanced fungal disease suppression and modulated expression of stress-related genes. ACS Sustain. Chem. Eng. 2019, 7, 19649–19659. [Google Scholar] [CrossRef]
- Elmer, W.; White, J.C. The future of nanotechnology in plant pathology. Annu. Rev. Phytopathol. 2018, 56, 111–133. [Google Scholar] [CrossRef]
- Du, J.; Liu, B.; Zhao, T.; Xu, X.; Lin, H.; Ji, Y.; Li, Y.; Li, Z.; Lu, C.; Li, P.; et al. Silica nanoparticles protect rice against biotic and abiotic stresses. J. Nanobiotechnol. 2022, 20, 197. [Google Scholar] [CrossRef]
- Zhao, L.; Lu, L.; Wang, A.; Zhang, H.; Huang, M.; Wu, H.; Xing, B.; Wang, Z.; Ji, R. Nano-biotechnology in agriculture: Use of nanomaterials to promote plant growth and stress tolerance. J. Agric. Food Chem. 2020, 68, 1935–1947. [Google Scholar] [CrossRef]
- Li, Y.; Zhang, P.; Li, M.; Shakoor, N.; Adeel, M.; Zhou, P.; Guo, M.; Jiang, Y.; Zhao, W.; Lou, B.; et al. Application and mechanisms of metal-based nanoparticles in the control of bacterial and fungal crop diseases. Pest Manag. Sci. 2023, 79, 21–36. [Google Scholar] [CrossRef]
- Wang, L.; Ning, C.; Pan, T.; Cai, K. Role of silica nanoparticles in abiotic and biotic stress tolerance in plants: A Review. Int. J. Mol. Sci. 2022, 23, 1947. [Google Scholar] [CrossRef]
- Kim, D.-Y.; Patel, S.K.S.; Rasool, K.; Lone, N.; Bhatia, S.K.; Seth, C.S.; Ghodake, G.S. Bioinspired silver nanoparticle-based nanocomposites for effective control of plant pathogens: A review. Sci. Total Environ. 2024, 908, 168318. [Google Scholar] [CrossRef]
- Li, H.; Chen, X.; Shen, D.; Wu, F.; Pleixats, R.; Pan, J. Functionalized silica nanoparticles: Classification, synthetic approaches and recent advances in adsorption applications. Nanoscale 2021, 13, 15998–16016. [Google Scholar] [CrossRef]
- Chen, S.; Guo, X.; Zhang, B.; Nie, D.; Rao, W.; Zhang, D.; Lü, J.; Guan, X.; Chen, Z.; Pan, X. Mesoporous silica nanoparticles induce intracellular peroxidation damage of Phytophthora infestans: A new type of green fungicide for late blight control. Environ. Sci. Technol. 2023, 57, 3980–3989. [Google Scholar] [CrossRef]
- Rajput, V.D.; Minkina, T.; Feizi, M.; Kumari, A.; Khan, M.; Mandzhieva, S.; Sushkova, S.; El-Ramady, H.; Verma, K.K.; Singh, A.; et al. Effects of silicon and silicon-based nanoparticles on rhizosphere microbiome, plant stress and growth. Biology 2021, 10, 791. [Google Scholar] [CrossRef]
- Rivero-Montejo, S.D.J.; Vargas-Hernandez, M.; Torres-Pacheco, I. Nanoparticles as novel elicitors to improve bioactive compounds in plants. Agriculture 2021, 11, 134. [Google Scholar] [CrossRef]
- Deng, Q.; Huang, S.; Liu, H.; Lu, Q.; Du, P.; Li, H.; Li, S.; Liu, H.; Wang, R.; Huang, L.; et al. Silica nanoparticles conferring resistance to bacterial wilt in peanut (Arachis hypogaea L.). Sci. Total Environ. 2024, 915, 170112. [Google Scholar] [CrossRef]
- Wang, L.; Pan, T.; Gao, X.; An, J.; Ning, C.; Li, S.; Cai, K. Silica nanoparticles activate defense responses by reducing reactive oxygen species under Ralstonia solanacearum infection in tomato plants. NanoImpact 2022, 28, 100418. [Google Scholar] [CrossRef]
- Kong, X.P.; Zhang, B.H.; Wang, J. Multiple roles of mesoporous silica in safe pesticide application by nanotechnology: A Review. J. Agric. Food Chem. 2021, 69, 6735–6754. [Google Scholar] [CrossRef]
- Suriyaprabha, R.; Karunakaran, G.; Kavitha, K.; Yuvakkumar, R.; Rajendran, V.; Kannan, N. Application of silica nanoparticles in maize to enhance fungal resistance. IET Nanobiotechnol. 2014, 8, 133–137. [Google Scholar] [CrossRef]
- Gao, Y.; Xiao, Y.; Mao, K.; Qin, X.; Zhang, Y.; Li, D.; Zhang, Y.; Li, J.; Wan, H.; He, S. Thermoresponsive polymer-encapsulated hollow mesoporous silica nanoparticles and their application in insecticide delivery. Chem. Eng. J. 2020, 383, 123169. [Google Scholar] [CrossRef]
- Yang, L.; Kaziem, A.E.; Lin, Y.; Li, C.; Tan, Y.; Huang, S.; Cheng, D.; Xu, H.; Zhang, Z. Carboxylated β-cyclodextrin anchored hollow mesoporous silica enhances insecticidal activity and reduces the toxicity of indoxacarb. Carbohydr. Polym. 2021, 266, 118150. [Google Scholar] [CrossRef]
- Grunberger, J.W.; Ghandehari, H. Layer-by-Layer Hollow mesoporous silica nanoparticles with tunable degradation profile. Pharmaceutics 2023, 15, 832. [Google Scholar] [CrossRef]
- Martin-Ortigosa, S.; Valenstein, J.S.; Lin, V.S.-Y.; Trewyn, B.G.; Wang, K. Gold functionalized mmesoporous silica nanoparticle mediated protein and DNA ccodelivery to plant cells via the biolistic method. Adv. Funct. Mater. 2012, 22, 3576–3582. [Google Scholar] [CrossRef]
- Cao, X.; Wang, C.; Luo, X.; Yue, L.; White, J.C.; Elmer, W.; Dhankher, O.P.; Wang, Z.; Xing, B. Elemental sulfur nanoparticles eenhance disease resistance in tomatoes. ACS Nano 2021, 15, 11817–11827. [Google Scholar] [CrossRef]
- Kong, X.; Zhang, C.; Zheng, H.; Sun, M.; Zhang, F.; Zhang, M.; Cui, F.; Lv, D.; Liu, L.; Guo, S.; et al. Antagonistic interaction between auxin and SA signaling pathways regulates bacterial infection through lateral root in Arabidopsis. Cell Rep. 2020, 32, 108060. [Google Scholar] [CrossRef]
- Ma, C.; Borgatta, J.; Hudson, B.G.; Tamijani, A.A.; De La Torre-Roche, R.; Zuverza-Mena, N.; Shen, Y.; Elmer, W.; Xing, B.; Mason, S.E.; et al. Advanced material modulation of nutritional and phytohormone status alleviates damage from soybean sudden death syndrome. Nat. Nanotechnol. 2020, 15, 1033–1042. [Google Scholar] [CrossRef] [PubMed]
- Abdelrhim, A.S.; Mazrou, Y.S.A.; Nehela, Y.; Atallah, O.O.; El-Ashmony, R.M.; Dawood, M.F.A. Silicon dioxide nanoparticles induce innate immune responses and activate antioxidant machinery in wheat against Rhizoctonia solani. Plants 2021, 10, 2758. [Google Scholar] [CrossRef] [PubMed]
- Zhao, P.; Yuan, W.; Xu, C.; Li, F.; Cao, L.; Huang, Q. Enhancement of spirotetramat transfer in cucumber plant using mesoporous silica nanoparticles as carriers. J. Agric. Food Chem. 2018, 66, 11592–11600. [Google Scholar] [CrossRef] [PubMed]
- Pan, W.; Zhang, H.J.; Zhang, Y.F.; Wang, M.; Tsui, M.T.K.; Yang, L.; Miao, A.J. Silica nanoparticle accumulation in plants: Current state and future perspectives. Nanoscale 2023, 15, 15079–15091. [Google Scholar] [CrossRef] [PubMed]
- Zhao, P.; Cao, L.; Ma, D.; Zhou, Z.; Huang, Q.; Pan, C. Translocation, distribution and degradation of prochloraz-loaded mesoporous silica nanoparticles in cucumber plants. Nanoscale 2018, 10, 1798–1806. [Google Scholar] [CrossRef] [PubMed]
- El-Shabrawy, E.M. Use Silica nanoparticles in controlling late wilt disease in maize caused by Harpophora Maydis. Egypt. J. Appl. Sci. 2021, 36, 1–19. [Google Scholar]
- Cui, J.; Liu, T.; Li, F.; Yi, J.; Liu, C.; Yu, H. Silica nanoparticles alleviate cadmium toxicity in rice cells: Mechanisms and size effects. Environ. Pollut. 2017, 228, 363–369. [Google Scholar] [CrossRef]
- Pokotylo, I.; Hodges, M.; Kravets, V.; Ruelland, E. A ménage à trois: Salicylic acid, growth inhibition, and immunity. Trends Plant Sci. 2022, 27, 460–471. [Google Scholar] [CrossRef] [PubMed]
- Pokotylo, I.; Kravets, V.; Ruelland, E. Salicylic Acid Binding Proteins (SABPs): The hidden forefront of salicylic acid signalling. Int. J. Mol. Sci. 2019, 20, 4377. [Google Scholar] [CrossRef]
- Wu, J.; Zhu, W.; Zhao, Q. Salicylic acid biosynthesis is not from phenylalanine in Arabidopsis. J. Integr. Plant Biol. 2023, 65, 881–887. [Google Scholar] [CrossRef]
- Kim, M.; Sung, J.-S.; Atchudan, R.; Syed, A.; Nadda, A.K.; Kim, D.-Y.; Ghodake, G.S. A rapid, high-yield and bioinspired synthesis of colloidal silver nanoparticles using Glycyrrhiza glabra root extract and assessment of antibacterial and phytostimulatory activity. Microsc. Res. Tech. 2023, 86, 1154–1168. [Google Scholar] [CrossRef] [PubMed]
- Kim, D.-Y.; Kim, M.; Sung, J.-S.; Koduru, J.R.; Nile, S.H.; Syed, A.; Bahkali, A.H.; Seth, C.S.; Ghodake, G.S. Extracellular synthesis of silver nanoparticle using yeast extracts: Antibacterial and seed priming applications. Appl. Microbiol. Biotechnol. 2024, 108, 150. [Google Scholar] [CrossRef] [PubMed]
- Fang, X.; Chen, C.; Liu, Z.; Liu, P.; Zheng, N. A cationic surfactant assisted selective etching strategy to hollow mesoporous silica spheres. Nanoscale 2011, 3, 1632–1639. [Google Scholar] [CrossRef] [PubMed]
- Bossert, D.; Urban, D.A.; Maceroni, M.; Ackermann-Hirschi, L.; Haeni, L.; Yajan, P.; Spuch-Calvar, M.; Rothen-Rutishauser, B.; Rodriguez-Lorenzo, L.; Petri-Fink, A.; et al. A hydrofluoric acid-free method to dissolve and quantify silica nanoparticles in aqueous and solid matrices. Sci. Rep. 2019, 9, 7938. [Google Scholar] [CrossRef] [PubMed]
- Zhu, J.; Tang, J.; Zhao, L.; Zhou, X.; Wang, Y.; Yu, C. Ultrasmall, well-dispersed, hollow siliceous spheres with enhanced endocytosis properties. Small 2010, 6, 276–282. [Google Scholar] [CrossRef]
- Schneider, C.A.; Rasband, W.S.; Eliceiri, K.W. NIH Image to ImageJ: 25 years of image analysis. Nat. Methods 2012, 9, 671–675. [Google Scholar] [CrossRef] [PubMed]
- Wang, Y.; Zhao, C.; Wang, X.; Shen, H.; Yang, L. Exogenous ethylene alleviates the inhibition of Sorbus pohuashanensis Embryo germination in a saline-alkali environment (NaHCO3). Int. J. Mol. Sci. 2023, 24, 4244. [Google Scholar] [CrossRef] [PubMed]
- Wang, L.-Y.; Zhang, Y.-F.; Yang, D.-Y.; Zhang, S.-J.; Han, D.-D.; Luo, Y.-P. Aureoverticillactam, a potent antifungal macrocyclic lactam from Streptomyces aureoverticillatus HN6, generates calcium dyshomeostasis-induced cell apoptosis via the phospholipase C pathway in Fusarium oxysporum f. sp. cubense Race 4. Phytopathology 2021, 111, 2010–2022. [Google Scholar] [CrossRef]
- Zhang, L.; Yuan, T.; Wang, Y.; Zhang, D.; Bai, T.; Xu, S.; Wang, Y.; Tang, W.; Zheng, S.-J. Identification and evaluation of resistance to Fusarium oxysporum f. sp. cubense tropical race 4 in Musa acuminata Pahang. Euphytica 2018, 214, 106. [Google Scholar]
- Chávez-Arias, C.C.; Gómez-Caro, S.; Restrepo-Díaz, H. Physiological responses to the foliar application of synthetic resistance elicitors in cape gooseberry seedlings infected with Fusarium oxysporum f. sp. physali. Plants 2020, 9, 176. [Google Scholar] [CrossRef]
- Jeger, M.J.; Viljanen-Rollinson, S.L.H. The use of the area under the disease-progress curve (AUDPC) to assess quantitative disease resistance in crop cultivars. Theor. Appl. Genet. 2001, 102, 32–40. [Google Scholar] [CrossRef]
- Szkop, M.; Szkop, U.; Kęszycka, P.; Gajewska, D. A simple and robust protocol for fast RP-HPLC determination of salicylates in foods. Food Anal. Methods 2017, 10, 618–625. [Google Scholar] [CrossRef]
- Kęszycka, P.K.; Szkop, M.; Gajewska, D. Overall content of salicylic acid and salicylates in food available on the european market. J. Agric. Food Chem. 2017, 65, 11085–11091. [Google Scholar] [CrossRef] [PubMed]

Disclaimer/Publisher’s Note: The statements, opinions and data contained in all publications are solely those of the individual author(s) and contributor(s) and not of MDPI and/or the editor(s). MDPI and/or the editor(s) disclaim responsibility for any injury to people or property resulting from any ideas, methods, instructions or products referred to in the content. |
© 2024 by the authors. Licensee MDPI, Basel, Switzerland. This article is an open access article distributed under the terms and conditions of the Creative Commons Attribution (CC BY) license (https://creativecommons.org/licenses/by/4.0/).
Share and Cite
Ding, C.; Zhang, Y.; Chen, C.; Wang, J.; Qin, M.; Gu, Y.; Zhang, S.; Wang, L.; Luo, Y. Hollow Mesoporous Silica Nanoparticles as a New Nanoscale Resistance Inducer for Fusarium Wilt Control: Size Effects and Mechanism of Action. Int. J. Mol. Sci. 2024, 25, 4514. https://doi.org/10.3390/ijms25084514
Ding C, Zhang Y, Chen C, Wang J, Qin M, Gu Y, Zhang S, Wang L, Luo Y. Hollow Mesoporous Silica Nanoparticles as a New Nanoscale Resistance Inducer for Fusarium Wilt Control: Size Effects and Mechanism of Action. International Journal of Molecular Sciences. 2024; 25(8):4514. https://doi.org/10.3390/ijms25084514
Chicago/Turabian StyleDing, Chaopu, Yunfei Zhang, Chongbin Chen, Junfang Wang, Mingda Qin, Yu Gu, Shujing Zhang, Lanying Wang, and Yanping Luo. 2024. "Hollow Mesoporous Silica Nanoparticles as a New Nanoscale Resistance Inducer for Fusarium Wilt Control: Size Effects and Mechanism of Action" International Journal of Molecular Sciences 25, no. 8: 4514. https://doi.org/10.3390/ijms25084514
APA StyleDing, C., Zhang, Y., Chen, C., Wang, J., Qin, M., Gu, Y., Zhang, S., Wang, L., & Luo, Y. (2024). Hollow Mesoporous Silica Nanoparticles as a New Nanoscale Resistance Inducer for Fusarium Wilt Control: Size Effects and Mechanism of Action. International Journal of Molecular Sciences, 25(8), 4514. https://doi.org/10.3390/ijms25084514

